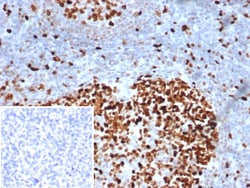
MCM3 Antibody (MCM3/6706), Novus Biologicals:Antibodies:Primary Antibodies

missing translation for 'onlineSavingsMsg'
Learn More
Learn More
MCM3 Antibody (MCM3/6706), Novus Biologicals™
Mouse Monoclonal Antibody
£178.00 - £351.00
Specifications
| Antigen | MCM3 |
|---|---|
| Clone | MCM3/6706 |
| Concentration | 0.2 mg/mL |
| Dilution | Immunohistochemistry-Paraffin : 1-2 μg/mL |
| Applications | Immunohistochemistry (Paraffin) |
| Product Code | Brand | Quantity | Price | Quantity & Availability | |||||
|---|---|---|---|---|---|---|---|---|---|
| Product Code | Brand | Quantity | Price | Quantity & Availability | |||||
|
18681735
|
Novus Biologicals
NBP3-23938-100ug |
100 μg |
£351.00
100µg |
Please sign in to purchase this item. Need a web account? Register with us today! | |||||
|
18624104
|
Novus Biologicals
NBP3-23938-20ug |
20 μg |
£178.00
20µg |
Please sign in to purchase this item. Need a web account? Register with us today! | |||||
Description
MCM3 Monoclonal antibody specifically detects MCM3 in Human samples. It is validated for Immunohistochemistry (Paraffin)Specifications
| MCM3 | |
| 0.2 mg/mL | |
| Immunohistochemistry (Paraffin) | |
| Unconjugated | |
| Mouse | |
| Cancer, Cell Cycle and Replication, Cellular Markers, Core ESC Like Genes, DNA Repair, Stem Cell Markers | |
| 10 mM PBS with 0.05% BSA | |
| 4172 | |
| IgG1 κ | |
| Protein A or G purified |
| MCM3/6706 | |
| Immunohistochemistry-Paraffin : 1-2 μg/mL | |
| Monoclonal | |
| Purified | |
| RUO | |
| Human | |
| cervical cancer proto-oncogene 5, DNA polymerase alpha holoenzyme-associated protein P1, DNA replication factor MCM3, DNA replication licensing factor MCM3, EC 3.6.4.12, HCC5, hRlf beta subunit, MCM3 minichromosome maintenance deficient 3, MCM3 minichromosome maintenance deficient 3 (S. cerevisiae), MGC1157, minichromosome maintenance complex component 3, minichromosome maintenance deficient (S. cerevisiae) 3, minichromosome maintenance deficient 3, P1.h, p102, P1-MCM3, replication licensing factor, beta subunit, RLF subunit beta, RLFB | |
| Recombinant fragment (aa 650-750) of human MCM3 protein (exact sequence is proprietary) | |
| Primary | |
| Store at 4°C. |
Spot an opportunity for improvement?Share a Content Correction
Product Content Correction
Your input is important to us. Please complete this form to provide feedback related to the content on this product.
Product Title